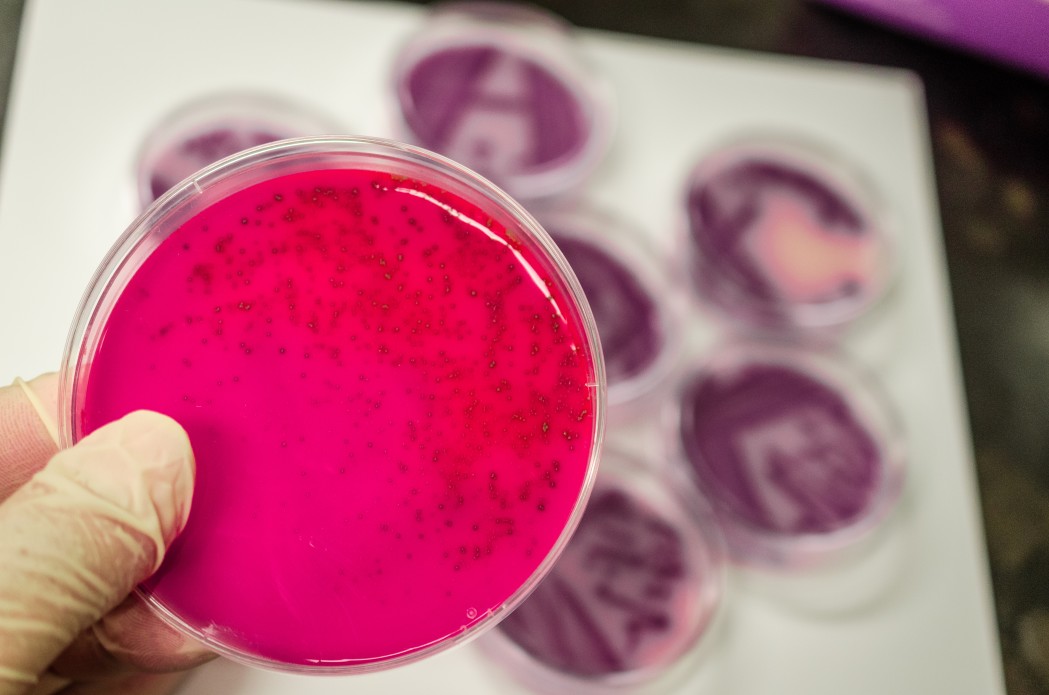

Vaccinations

Hepatitis A
Hepatitis A is a contagious disease of the liver caused by Hepatovirus A (HAV).
It is communicable disease usually transmitted from person to person through the fecal-oral route or by
consumption of contaminated water and food. It can be spread through direct exposure to the infected person.
Many cases have few or no symptoms, especially in the young.
SIGNS AND SYMPTOMS
Symptoms usually last less than 2months, although some people can be ill for as long as 6 months.



Hepatitis B
HBV can cause infection and inflammation to the liver. Hepatitis B can range from a mild illness lasting a few weeks to a serious lifelong illness.
It’s two types are:
-Acute Hepatitis B & Chronic Hepatitis B
SIGNS AND SYMPTOMS
Symptoms of Hepatitis B are as follows:





Malaria
Malaria is an infectious disease caused by a parasite.
It is spread by the bite of an infected mosquito.
When parasite enters the blood then people catch malaria.
SIGNS AND SYMPTOMS
Most people get symptoms 10-30days after they get infected.



Typhoid
Typhoid is a bacterial infection caused by salmonella typhi. It grows in intestines and bloods.
It ranges from mild to severe and usually begin 6 to 30 days after exposure.
This causes weakness, abdominal pain ,constipation , headache and mild vomiting.
SIGNS AND SYMPTOMS
The incubation period is 1-2weeks,and the duration of the illness is about 4-6 weeks. The complications are :

Support Given
Clients Rating

